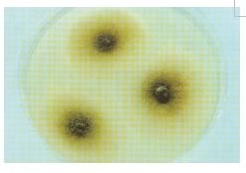
麴黴病

發病機制
煙麴黴的菌落特徵
煙麴黴的菌落特徵 黑麴黴
黑麴黴臨床表現
 黃麴黴
黃麴黴 麴黴病組織
麴黴病組織實驗檢查
 麴黴病
麴黴病病理說明
 麴黴病
麴黴病診斷說明
 植物中的白麴黴
植物中的白麴黴其診斷要點為:1.反覆作真菌直接塗片和培養,直接檢查可見分隔菌絲,培養可得煙麴黴、黃麴黴、黑麴黴、土麴黴、雜色麴黴、小巢形麴黴、花斑麴黴等。2.病理組織檢查對診斷有決定性意義,可見排列成放射狀、分隔的菌絲,7~10μm盲徑,向一個方向呈45°角分支,蘇木紫-伊紅染色呈嗜鹼性的麴黴。有時表現為平行的、分支不多的分隔菌絲,或可見孢子頭,甚至孢子狀(菌絲橫切面)。組織改變可為壞死性、化膿性或肉芽腫性。3.臨床表現不能用其他疾病來解釋者。4.存在各種誘發因素。
治療說明
由於麴黴廣布於自然界,因此必須加強防護措施以預防感染。在粉塵多的環境應戴口罩。脫粒時稻穀飛入眼內,切勿用力擦眼,應及時用生理鹽水沖洗,以免角膜擦傷。對眼和皮膚等外傷應及時處理,手術器械必須嚴格消毒,以防真菌污染。應盡力減少誘發因素的影響,對肺結核、慢性支氣管炎、支氣管哮喘、支氣管擴張等原發病應予積極治療。耳麴黴可用3%硼酸、5%醋酸鋁、2%水楊酸酒精溶液將耳垢輕輕洗去,然後以2%龍膽紫塗搽,或滴入1%~3%克霉唑丙二醇溶液或制黴菌素(10萬u/ml)溶液(或軟膏塗搽)。眼麴黴性潰瘍可用金褐黴素0.1%溶液或1%軟膏塗眼,痊癒率分別為76%及79%。此外,0.2%兩性黴素B溶液或1%兩性黴素B眼膏也可套用,治癒率可達半數以上。呼吸道麴黴病可用兩性黴素B噴霧,每日1次。此外,肺及其他較深部位麴黴病,尤其是麴黴敗血症,應以全身治療為主,可用兩性黴素B靜滴、同時口服5-氟胞嘧啶等。後兩者單獨套用效果不佳。近年來有用氟康唑或伊曲康唑治癒本病的報告。類別
熏煙色麴黴、黑麴黴、黃麴黴、土麴黴、米麴黴、棒麴黴、雜色麴黴、構巢麴黴、薩氏麴黴、灰綠麴黴等,其中的熏煙色麴黴最多見。相關
疾病真菌感染
生物致病因子和生物源性疾病
疾病大全(一)
| 疾病是人體健康的殺手,了解疾病、預防疾病、治療疾病一直是廣大醫務工作者為之奮鬥的目標。然而預防疾病也是我們每個人必須做到的。在這裡讓我們通過對一些疾病的了解來加強人類對疾病的防範意識,杜絕疾病的發生,減少人間的慘劇! |
